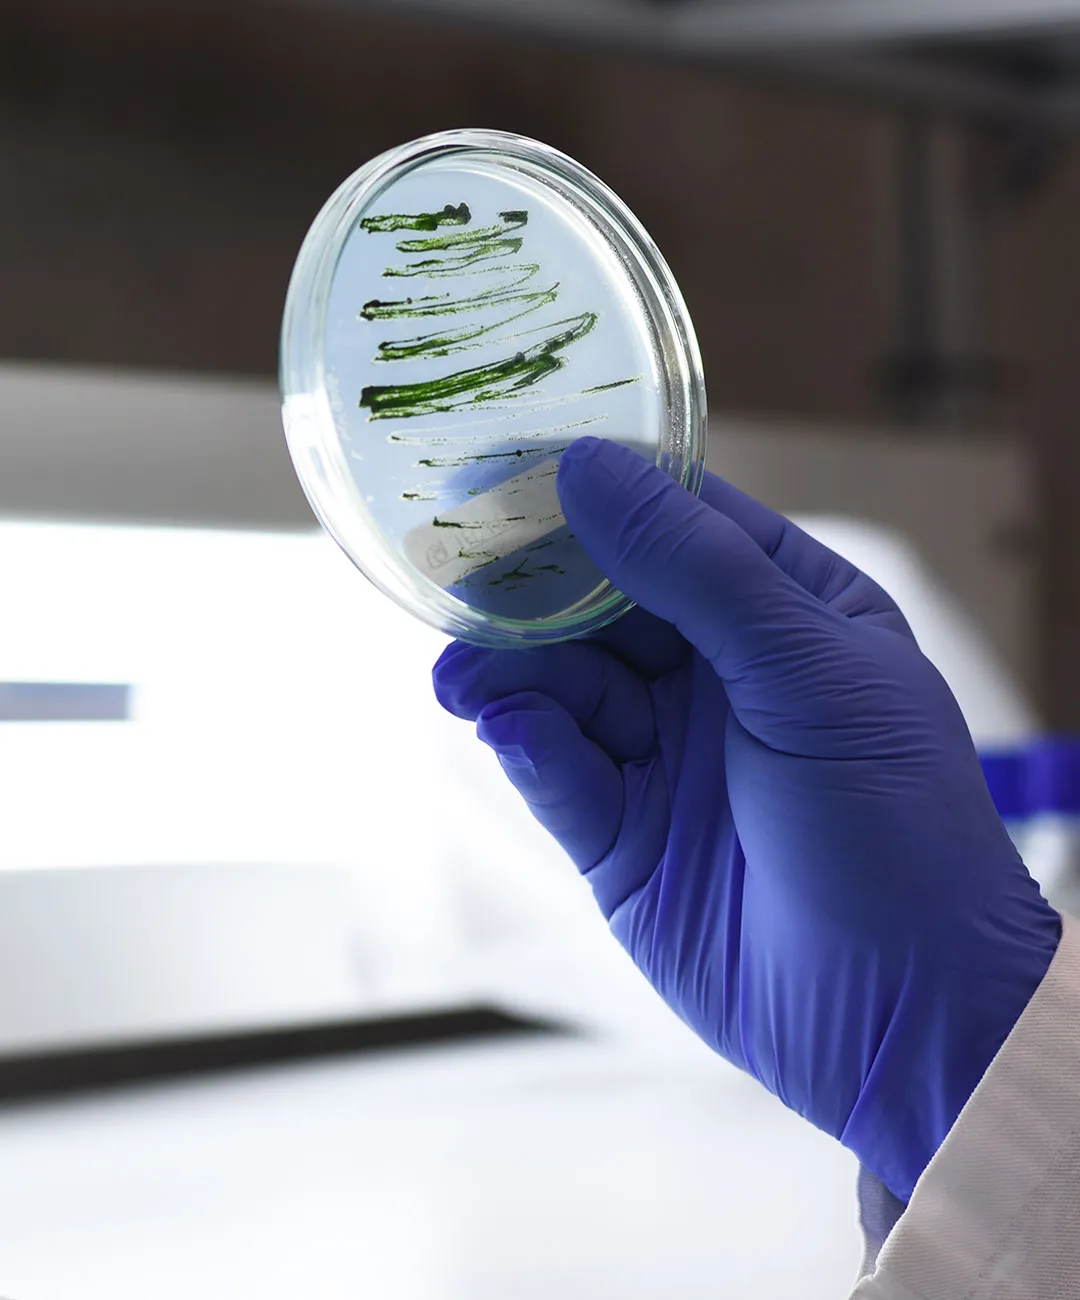

BIO TECHwith Science Innovation
藻類の可能性を拓くバイオサイエンス
ABOUT
藻類の可能性地球に新しい未来を創る
藻類を活用したバイオテクノロジーを通じて、経済的価値の創出と社会的課題の解決を追求します。CO₂削減やバイオ燃料の開発をはじめ、美容・医療・食品など多様な産業分野への応用を視野に、藻類に関する研究開発に取り組んでいます。
また、持続可能な資源利用・食料安全保障・医療革新といった観点から、SDGsを基軸に産業の発展を寄与し、豊かで持続可能な社会の実現を目指します。
事業内容
BUSINESS
藻類を活用した
産業イノベーション
藻類の活用は今後の産業・暮らしに欠かせないバイオテクノロジーとして注目されており、幅広い分野への応用が進んでいます。企業においては事業や経営戦略に即した形で藻類の可能性を生かし、産業の発展に向けて取り組んでいます。
-

Research contract
研究委託事業
藻類培養研究
内製化サポート

-

Supplyment
原材料供給事業
美容・医療・食品分野における
製品原料の供給

-

Operation system
環境インフラ導入
バイオマス燃料開発
環境インフラの構築

PROJECT

サステナブル設備導入
プロジェクト
エネルギー・水・廃棄物などの環境課題に対応する、実用的な設備ソリューションを提供します。脱炭素や循環型社会の実現に向けて、企業・自治体への現場導入を支援します。
山川町漁業協同組合と手を取り、牛の飼料としてカギケノリを養殖。牛から出るゲップの脱炭素と、海の生態系の回復に取り組んでいます。

原料紹介
藻類由来の取扱い原料
美容・健康・食品・医療・農業など、さまざまな分野で活用できる藻類由来の高機能原料を提供しています。科学的なエビデンスに基づく高い機能性と、安定した供給体制により、製品開発に信頼してご活用いただけます。
製品紹介
PRODUCT
バイオリアクターの導入
藻類の培養に関わるあらゆる要素を制御し、CO₂を常に消費しながら酸素を排出する藻類バイオリアクターの導入により、藻類の大量培養を低コストで実現しています。さらに、CO₂削減やバイオ燃料の生産を通じて、「環境浄化」や「クリーンエネルギーへの転換」の社会的課題の解決に貢献しています。








